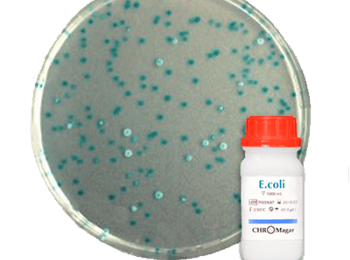
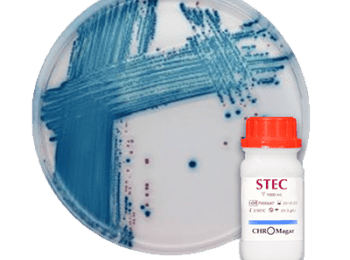
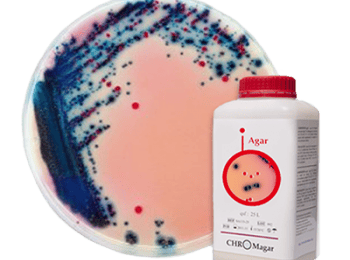
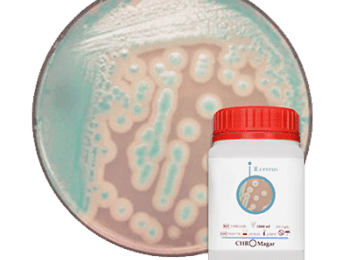

Medio de Cultivo - Serco Comercial
-
Disponibilidad de Medio de Cultivo - Serco Comercial:En stock
Descripción de Medio de Cultivo - Serco Comercial:
Los medios de cultivo que ofrecemos permiten identificar una amplia variedad de microorganismos en alimentos, agua y entornos clínicos o industriales. Nuestros medios cromogénicos agilizan la detección, facilitan la interpretación por color y garantizan resultados confiables en procesos de control microbiológico.
Los medios de cultivo que ofrecemos permiten identificar una amplia variedad de microorganismos en alimentos, agua y entornos clínicos o industriales. Nuestros medios cromogénicos agilizan la detección, facilitan la interpretación por color y garantizan resultados confiables en procesos de control microbiológico.


-
Cobertura de Medio de Cultivo - Serco Comercial Nacional
-
De Medio de Cultivo - Serco Comercial somos Distribuidor
4.8
Gabriela Ramirez Jimenez
3 años atrás
robert chavolla
8 años atrás
ale kim
8 años atrás
GABRIEL MENDOZA
7 años atrás
¡Atención! Las opiniones expuestas se toman de las que los usuarios escribieron en el registro de Google de esta empresa. No son directamente de nuestra plataforma en Cosmos. Te sugerimos validar tú mismo esta información.


-
Cobertura de Medio de Cultivo - Serco Comercial Nacional
-
De Medio de Cultivo - Serco Comercial somos Distribuidor
4.8
Gabriela Ramirez Jimenez
3 años atrás
robert chavolla
8 años atrás
ale kim
8 años atrás
GABRIEL MENDOZA
7 años atrás
¡Atención! Las opiniones expuestas se toman de las que los usuarios escribieron en el registro de Google de esta empresa. No son directamente de nuestra plataforma en Cosmos. Te sugerimos validar tú mismo esta información.
Otros productos que vende Serco Comercial

$ 22,700 MXN
Min. Caja con 100




$ 22,700 MXN
Min. Caja con 100



Tal vez te interesa
¿Necesitas una cotización personalizada?
Nuestro equipo técnico puede ayudarte a seleccionar Medio de Cultivo - Serco Comercial ideal según tu línea de producción, velocidad y tipo de material.